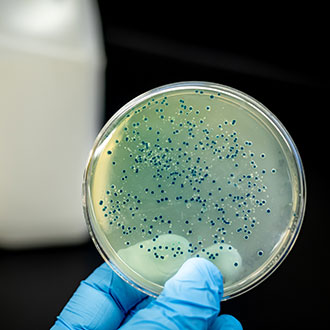
Curso en Prevención de Legionelosis y Gestión de Instalaciones de Riesgo

Máster de Formación Permanente en Innovación y Gestión en la Industria Química
Máster acreditado por EUNEIZ


Máster acreditado por EUNEIZ


Curso acreditado por ADISDE


Curso acreditado por UTAMED


Curso acreditado por UTAMED


Curso acreditado por EUNEIZ


Curso acreditado por EUNEIZ


Curso acreditado por UTAMED


Curso acreditado por UTAMED


Curso acreditado por EUNEIZ


Curso acreditado por EUNEIZ


Curso acreditado por EUNEIZ


Curso acreditado por EUNEIZ


Curso acreditado por EUNEIZ

Curso acreditado por UTAMED


Curso acreditado por EUNEIZ


Curso acreditado por UTAMED


Curso acreditado por UTAMED


Curso acreditado por UTAMED


Curso acreditado por EUNEIZ


Curso acreditado por UTAMED


Curso acreditado por UTAMED
La Química es una ciencia fundamental para sectores estratégicos como la industria farmacéutica, alimentación, energía, medio ambiente, cosmética o investigación. Su aplicación está presente en el desarrollo de materiales, control de calidad, innovación tecnológica y mejora de procesos productivos. Por ello, los Cursos, Expertos, Especialistas y Máster Online para Química se han convertido en una excelente opción para especializarse, actualizar conocimientos y mejorar la proyección profesional.
Gracias a la modalidad online, hoy es posible ampliar formación en química analítica, laboratorio, control de calidad, química industrial, seguridad o sostenibilidad con total flexibilidad y sin renunciar al trabajo u otras responsabilidades.
Se trata de programas formativos orientados al desarrollo de competencias científicas, técnicas y aplicadas relacionadas con el estudio de la materia, sus transformaciones y sus usos industriales o sanitarios.
Dependiendo del nivel académico y la especialización buscada, puedes encontrar:
Entre los contenidos más habituales destacan:
La especialización en este ámbito abre oportunidades en industria, laboratorios, sanidad, investigación y consultoría.
También es una formación muy interesante para técnicos de laboratorio, ingenieros, sanitarios, docentes y perfiles STEM.
Elegir una formación online permite seguir creciendo profesionalmente con máxima flexibilidad. Cada vez más alumnos optan por estudiar química online.
Muchos programas cuentan con acreditación universitaria, un valor añadido relevante para procesos de selección y méritos académicos. Además, según las bases de cada convocatoria, estas titulaciones pueden ser puntuables y baremables en oposiciones, bolsas públicas de empleo y concursos de méritos.
Si te preguntas qué estudiar para trabajar en laboratorio o cómo especializarme en química aplicada, esta categoría ofrece excelentes oportunidades.
Actualmente puedes cursar esta formación en distintas modalidades:
Los requisitos dependen del programa elegido. Algunos cursos están abiertos a personas interesadas en ciencia aplicada, mientras que expertos, especialistas y másteres pueden dirigirse a titulados universitarios o perfiles con conocimientos previos.
La duración varía desde cursos breves hasta programas avanzados de varios meses.
Antes de matricularte, conviene revisar varios aspectos importantes:
Elegir correctamente puede ayudarte a diferenciarte en sectores científicos e industriales con alta demanda.
Sí. Puede abrir oportunidades en laboratorios, industria, calidad, investigación, sanidad o docencia.
Muchos programas pueden ser baremables y puntuables, siempre según las bases específicas de cada convocatoria pública.
No siempre. Existen cursos introductorios y otros avanzados orientados a perfiles especializados.
Los Cursos, Expertos, Especialistas y Máster Online para Química son una excelente oportunidad para ampliar conocimientos, mejorar tu currículum y crecer profesionalmente. Si buscas nuevas oportunidades en un sector científico con gran proyección, esta formación puede ser tu siguiente paso estratégico.